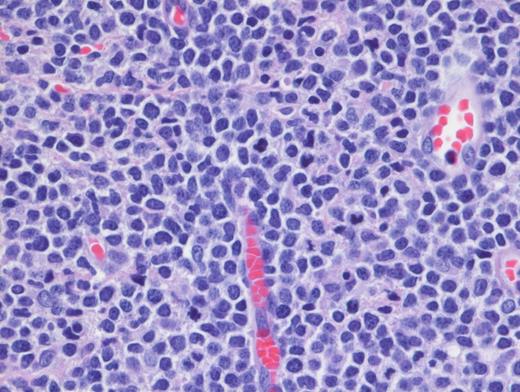
High-Power H&E. High-power demonstrates blastoid medium-sized lymphoid cells with dispersed chromatin (magnification x100).

A 15-year-old girl presented with a three-month history of an erythematous rash on the medial side of the left breast. This was initially diagnosed as extramedullary myeloid tumor (EMMT). The patient received standard therapy for acute myeloid leukemia. Although bone marrow and cerebrospinal fluid analysis at the end of therapy showed no evidence of disease, there was cutaneous relapse in three months. An excisional skin biopsy was performed and showed an extensive/malignant appearing infiltrate involving dermis and underlying soft tissue and sparing epidermis and adnexal structures. Images of low- and high-power hematoxylin and eosin (H&E; Figures 1 and 2) as well as CD4 (Figure 3) and CD123 (Figure 4) immunostains are shown. In addition to these markers, a panel of immunostains revealed the dermal infiltrate to be positive for TdT, CD33, CD43, CD45, TCL1, TCF4, and CD68 KP1 (faint, focal).
Additionally, cytogenetics showed RB1 deletion and loss of chromosome 17.
Low-Power H&E. Extensive, monotonous infiltrate composed of small- to medium-sized cells extending into the dermis. The epidermis is not involved (magnification x400).
Low-Power H&E. Extensive, monotonous infiltrate composed of small- to medium-sized cells extending into the dermis. The epidermis is not involved (magnification x400).
High-Power H&E. High-power demonstrates blastoid medium-sized lymphoid cells with dispersed chromatin (magnification x100).
High-Power H&E. High-power demonstrates blastoid medium-sized lymphoid cells with dispersed chromatin (magnification x100).
A. EMMT
B. Blastic plasmacytoid dendritic cell neoplasm (BPDCN)
C. T-lymphoblastic lymphoma (T-LBL) with aberrant CD33 expression
D. Histiocytic sarcoma
Sorry, that was not the preferred response.
Correct!
TBPDCN is a rare, clinically aggressive neoplasm seen typically in adults. It has been rarely reported in the pediatric population. The disease tends to involve multiple sites, but skin is a common location. BPDCN is characterized by a monotonous infiltrate composed of undifferentiated medium-sized blastic cells with dispersed chromatin. The infiltrate spares epidermis and adnexal structures but extends deeply into the subcutaneous tissue. The typical immunophenotypic profile is CD4+, CD56+, and CD123+ neoplasm. However, a subset of cases (8%) are CD56-negative. An extensive panel of immunohistochemical stains (including TCL1A, CD303, and more recently, TCF4) further help to diagnose. Whenever possible, both flow cytometry and cytogenetics should be performed.
Differential diagnosis with EMMT is challenging,1 particularly in CD56-negative cases. In this case, the faint expression of CD68 (KP1) coupled with CD33 and CD43 expression was suggestive of EMMT. However, CD33 and CD43 positivity can be seen in both BPDCN and EMMT. Furthermore, CD4 is commonly expressed in myeloid sarcomas with monocytic differentiation, especially in NPM1-mutated cases. Diffuse positivity for CD123 in a CD4+/TdT+ malignant neoplasm should alert the pathologist for a diagnosis of BPDCN even in the absence of CD56. In this case, additional TCF4 and TCL1 were eventually performed and showed diffuse positivity. The former marker (TCF4) is a crucial marker expressed in blastic cells with differentiation towards PDCs and its positivity allows exclusion of myeloid lineage. Dual expression of TCF4 and CD123 was found to be sensitive and specific for BPDCN.2 The distinction is critical since pediatric BPDCN patients benefit from lymphoid-directed therapy. A novel CD-123 directed targeted therapy3 was also recently approved by the U.S. Food and Drug Administration for adults and pediatric patients with this disease.
T-LBL with aberrant CD33 positivity is a possibility in a TdT+, CD4+, CD43+ skin lesion. However, most cases would also express CD3 by immunohistochemistry due to antibody recognition of the cCD3 epsilon chain. CD34 and CD1a are generally positive in T-LBL and can help with this differential diagnosis. In our case, CD34 was negative.
Histiocytic sarcoma is a rare neoplasm which can occur in children. It can present with skin manifestations including a benign-appearing rash. The cellular morphology and the uniform size with scant cytoplasm is not typical for histiocytic sarcoma which shows prominent pleomorphism with abundant cytoplasm. While CD4, CD43, CD45, and CD68 positivity (seen in this case) are supportive of histiocytic sarcoma, the expression of TdT, TCF4, TCL1, and CD123 are not in keeping with this diagnosis.
References
References
Dr. Gheorghe and Dr. Venkataraman indicated no relevant conflicts of interest.